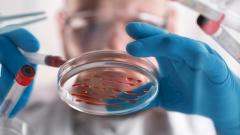
лечение редкого детского рака

Ученые рассказали о многообещающем лечении редкого детского рака
Ученые обнаружили способ лечения альвеолярной рабдомиосаркомы — редкого вида рака у детей, сообщает Medical Xpress.
Альвеолярная рабдомиосаркома — редкая опухоль, разрастающиеся в мышечной ткани в основном у детей и подростков. В Европе ежегодно диагностируется около 500 новых случаев рабдомиосаркомы, из которых 100 — альвеолярная рабдомиосаркома. Несмотря на многие достижения в терапии рака, за последние 40 лет лечение рабдомиосаркомы не изменилось. Выживаемость в течение пяти лет после обнаружения болезни составляет всего 30%.
Ученые под руководством профессора Антона Хенссена из Университета Шарите в Берлине нашли новое лечение с использованием препарата, который уже исследуется для лечения других видов рака. Онкологи обнаружили, что раковые клетки альвеолярной рабдомиосаркомы имеют высокий уровень повреждения ДНК и больше зависят от процессов восстановления, чем нераковые клетки.
Альвеолярная рабдомиосаркома характеризуется транслокацией хромосом и созданием нового слитого белка PAX3-FOXO1. Кроме слияния PAX3-FOXO1, этот вид рака не показывает многие повторяющиеся генетические мутации, что ограничивает использование лекарств. Однако ученые выяснили, что альвеолярная рабдомиосаркома более чувствительна к ингибиторам, нацеленным на ATR — белок, необходимый для восстановления ДНК.
Исследователи идентифицировали PAX3-FOXO1 как фактор, который увеличивает повреждение ДНК в раковых клетках, что делает их более уязвимыми к дефициту восстановления повреждений ДНК. Подавляя ATR, клетки накапливают повреждения ДНК. По сути, их принуждают к клеточному самоубийству — так называемому апоптозу.
«Когда мы тестировали лекарства на мышах, у которых развились альвеолярные рабдомиосаркомы, полученные от пациента, мы обнаружили, что ингибиторы ATR обладают сильной противоопухолевой активностью, делая лекарства на один шаг ближе к пациенту», — отметил Хенссен.
Теперь в США готовится новое исследование тестирования ингибиторов ATR, для которого набирают пациентов с редкими детскими опухолями, включая альвеолярную рабдомиосаркому. Потенциал ингибиторов ATR в лечении рака, отдельно или в сочетании с другими препаратами, нуждается в дальнейшем изучении в будущих исследованиях.
Академик РАН заявил о нехватке в России оборудования для борьбы с саркомой